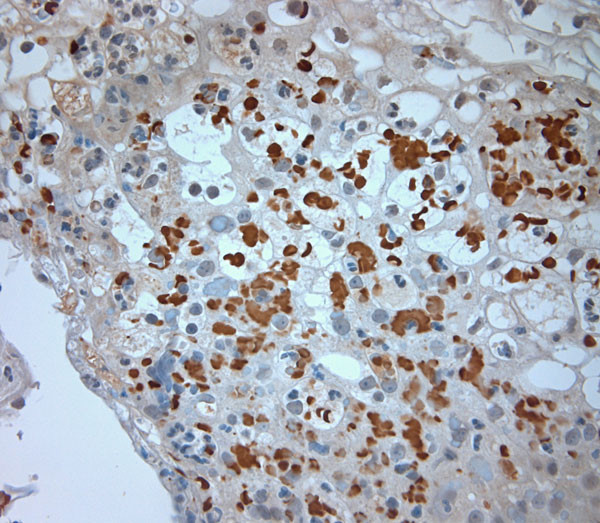
CLCN6 Antibody in Immunohistochemistry (Paraffin) (IHC (P))

Search
Osenses
CLCN6 Polyclonal Antibody
{{$productOrderCtrl.translations['antibody.pdp.commerceCard.promotion.promotions']}}
{{$productOrderCtrl.translations['antibody.pdp.commerceCard.promotion.viewpromo']}}
{{$productOrderCtrl.translations['antibody.pdp.commerceCard.promotion.promocode']}}: {{promo.promoCode}} {{promo.promoTitle}} {{promo.promoDescription}}. {{$productOrderCtrl.translations['antibody.pdp.commerceCard.promotion.learnmore']}}
图: 1 / 5
CLCN6 Antibody (OSC00147W-100UL) in IHC (P)





产品信息
OSC00147W-100UL
种属反应
已发表种属
宿主/亚型
分类
类型
抗原
偶联物
形式
浓度
保存液
内含物
保存条件
运输条件
产品详细信息
Reconstitute in 100 µL of sterile water. Centrifuge to remove any insoluble material.
Specificity of this antibody: CLCN6.
靶标信息
This gene encodes a member of the voltage-dependent chloride channel protein family. Members of this family can function as either chloride channels or antiporters. This protein is primarily localized to late endosomes and functions as a chloride/proton antiporter. Alternate splicing results in both coding and non-coding variants. Additional alternately spliced variants have been described but their full-length structure is unknown. [provided by RefSeq, Mar 2012].
仅用于科研。不用于诊断过程。未经明确授权不得转售。
生物信息学
蛋白别名: Chloride channel protein 6; chloride channel, voltage-sensitive 6; Chloride transport protein 6; ClC-6; ClC-6d; D1-A2; H(+)/Cl(-) exchange transporter 6; KIAA0046; unnamed protein product
基因别名: CLC-6; CLCN6; CONRIBA; KIAA0046
UniProt ID: (Human) P51797
Entrez Gene ID: (Human) 1185